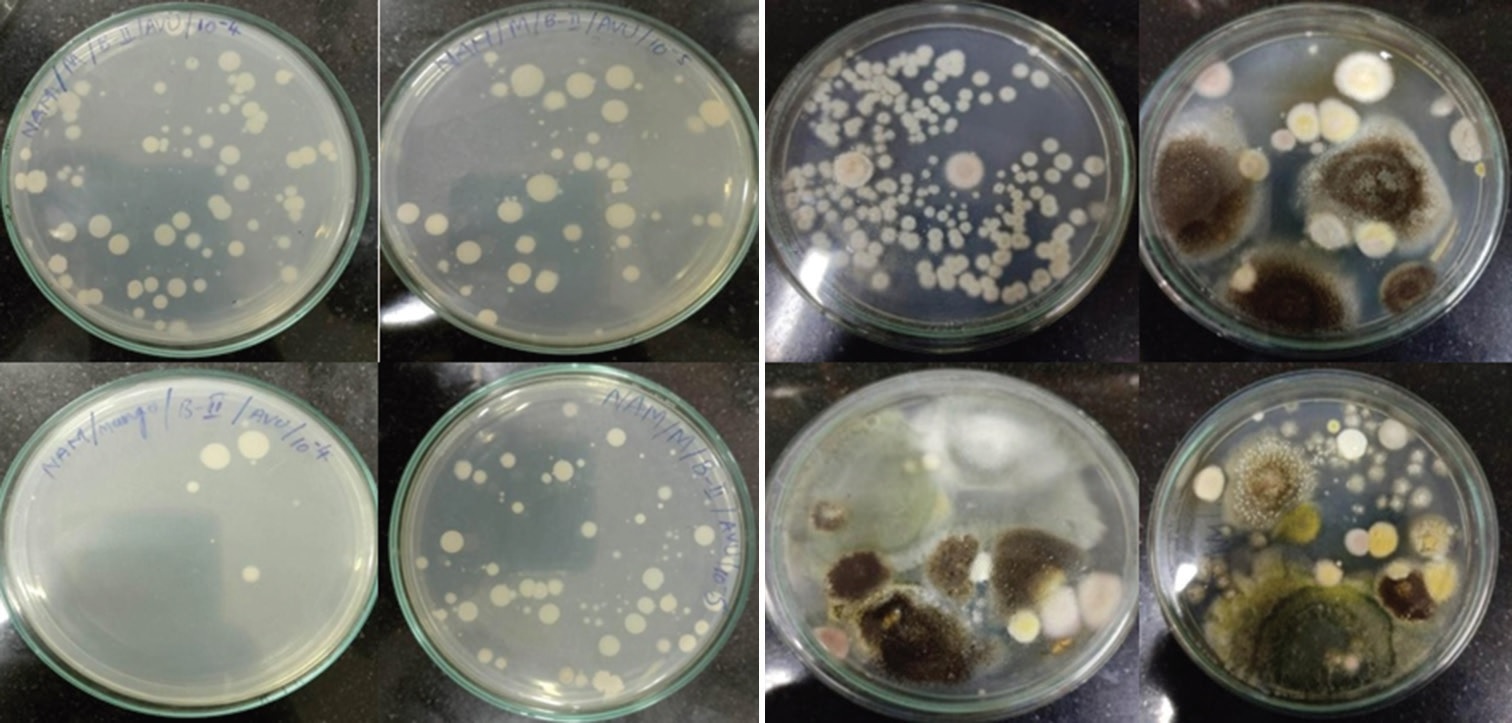
Article Image

Issue Details

May, 2024
Volume: 12, Issue: 2
📅 Published on: 05 May 2024
Articles in this Issue
Fabrication of Functionally Modified Alginate-based pH-Responsive Hydrogels and their Silver Nanocomposites for Biomedical Applications
Authors: D. Hemalatha, Chandra Sekhar Espenti, K. Riazunnisa, K. S. V. Krishna Rao*
DOI: 10.22607/IJACS.2024.1202001 | Pages: 69-77

Inhibitors of Lignin-Associated Polymers: Origin, Impact, and Control in Bioethanol Production
Authors: B. V. Sivaprasad, M. Subhosh Chandra*, P. Suresh Yadav, T. Chandrasekhar, K. Riazunnisa, K. Harika, A. Muni Kumari
DOI: 10.22607/IJACS.2024.1202002 | Pages: 78-92

Theoretical Structure for Evaluating the Effects of Water Contamination on the Economy and Environment: A Detailed Study on Sustainable Development of India (Review Article)
Authors: C. Krupavathi, S. Srinivasa Gowd*, P. Ravi Kumar
DOI: 10.22607/IJACS.2024.1202005 | Pages: 104-112

Chemical Characterization of Guiera senegalensis Leaves Organic Extracts and Their Antibacterial Activity: A Plant of the Senegalese Pharmacopeia
Authors: El Hadji Gorgui Diouf*, Mamadou Latyr Ndoour, Alioune Diouf, Adama Faye, Mamadou Kébé, Talibouya Ndior
DOI: 10.22607/IJACS.2024.1202006 | Pages: 113-117

Hydrogeochemical Evaluation of Groundwater Quality for Drinking and Irrigation Purposes using Water Quality Index, and Geospatial Techniques in Parts of Semi-arid Regions, Andhra Pradesh, India
Authors: P. Ravi Kumar, S. Srinivasa Gowd, C. Krupavathi
DOI: 10.22607/IJACS.2024.1202008 | Pages: 124-133